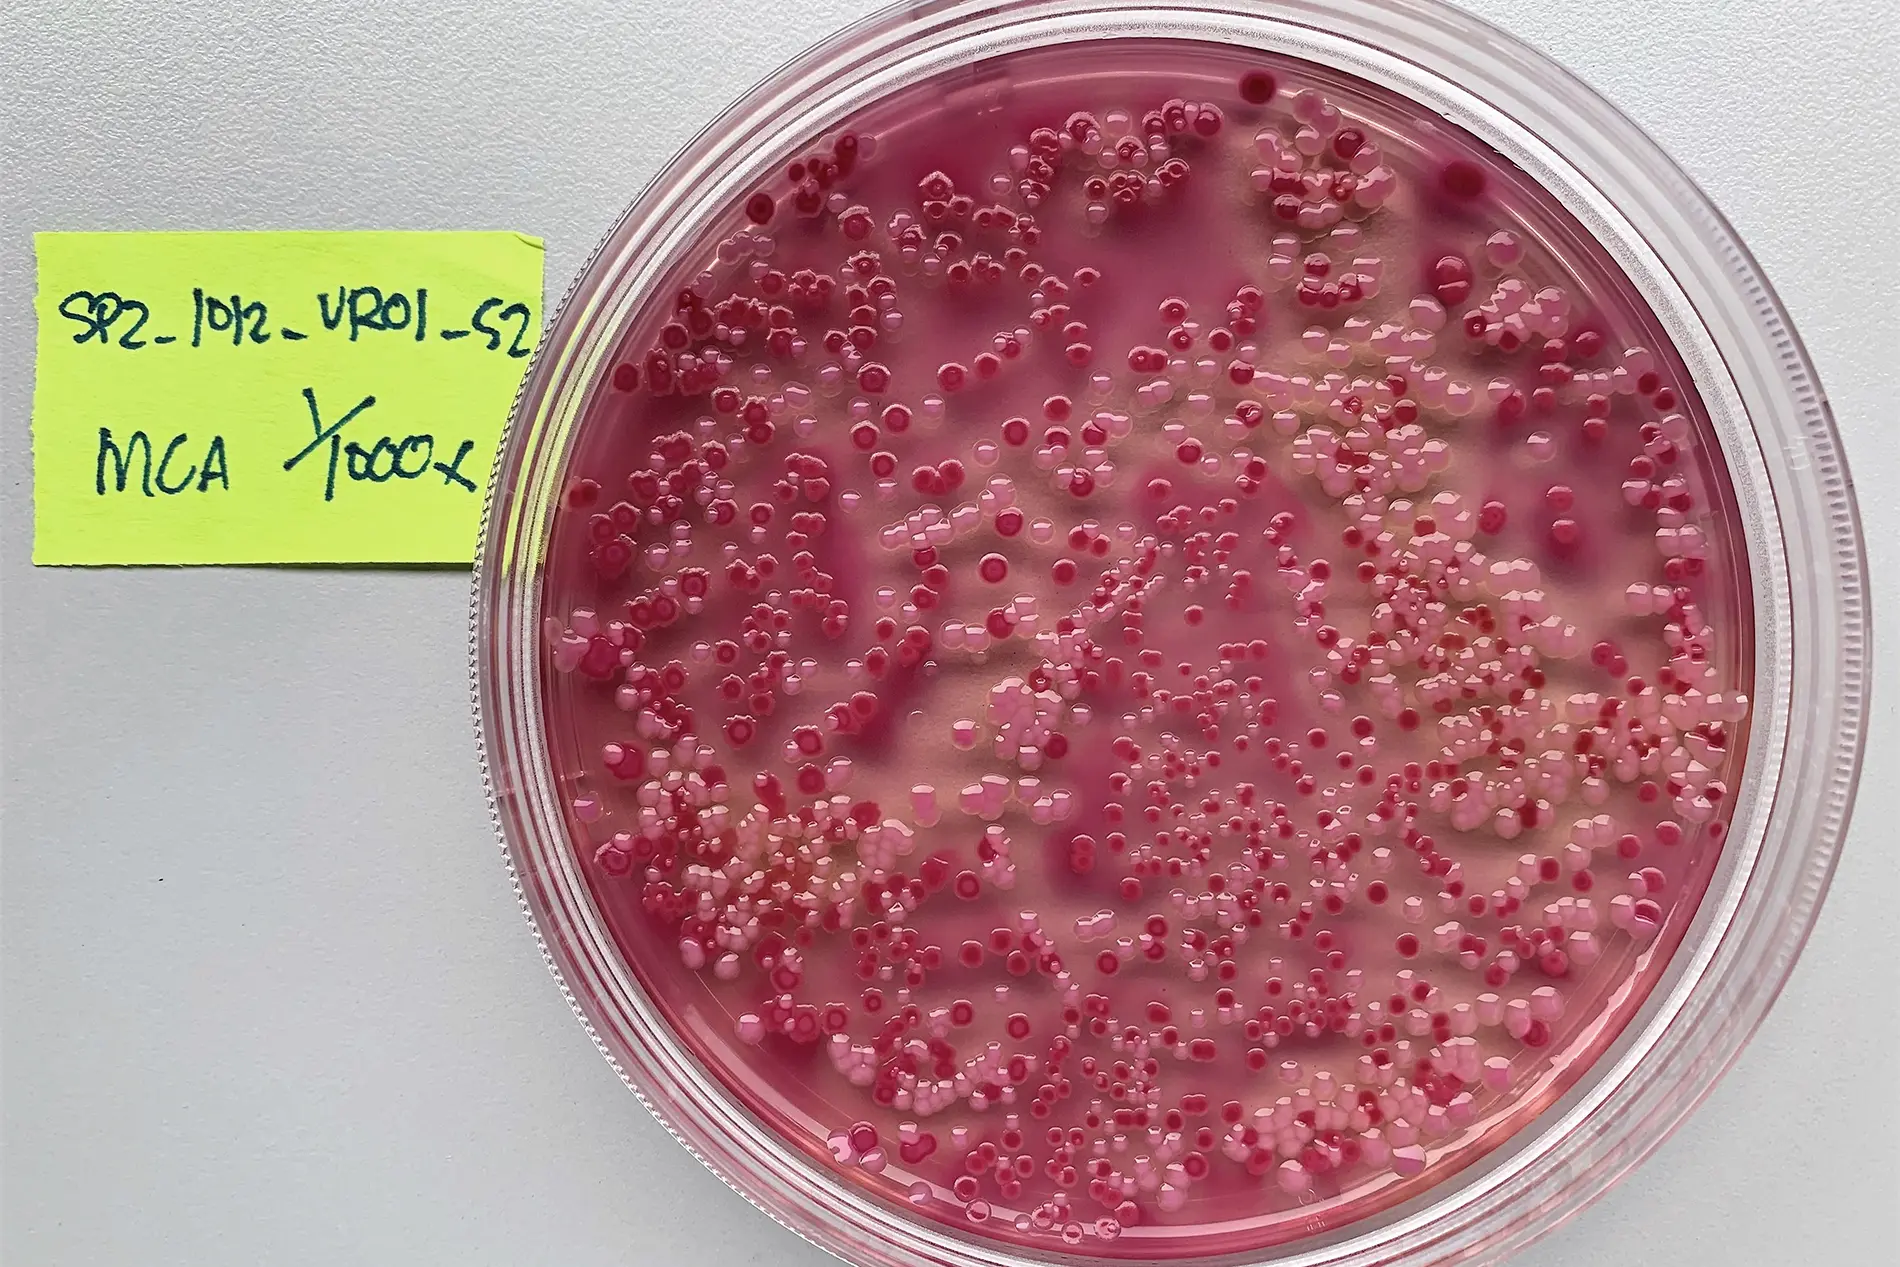

Contro l’antibiotico-resistenza, a pesca di batteri
Identificare rapidamente alcuni batteri permette di ottimizzare i trattamenti antibiotici. Con il sostegno del FNS, un team dell’Università di Zurigo ha sviluppato molecole in grado di riconoscere e catturare determinate specie.
La scoperta degli antibiotici ha rivoluzionato la medicina del XX secolo e salvato numerose vite umane. Tuttavia, la comparsa di batteri resistenti si è rapidamente imposta come una nuova sfida. Una delle chiavi nella lotta contro questa minaccia è la capacità di identificare in modo preciso i batteri responsabili di un’infezione. Ciò consente di utilizzare antibiotici mirati ed efficaci, riducendo così il rischio di insorgenza di nuove resistenze.
Grazie al sostegno del Fondo nazionale svizzero (FNS), alcuni ricercatori hanno sviluppato delle molecole in grado di riconoscere alcuni batteri più rapidamente di quanto avvenuto finora. Le loro ricerche sono state pubblicate di recente nella rivista Communications Biology (*). Questi risultati aprono la strada a metodi diagnostici più rapidi, in particolare per le infezioni del sangue, ma non solo. «Le molecole sviluppate sono già utilizzate nell’ambito di un partenariato avviato con la start-up zurighese Rqmicro, impegnata nella messa a punto di strumenti per il monitoraggio della qualità dell’acqua», afferma soddisfatto il biochimico Markus Seeger, che ha condotto lo studio presso l’Istituto di microbiologia medica dell’Università di Zurigo.
Accelerare i tempi di alcune diagnosi
«Nella corsa tra l’evoluzione batterica dell’antibiotico-resistenza e lo sviluppo di nuovi antibiotici non abbiamo alcuna possibilità di vincere, afferma il ricercatore». I batteri sono in guerra con i virus da diversi milioni di anni e sono abituati a evolvere per sfuggire a nuove minacce». Attualmente, l’unica soluzione è un utilizzo attento e mirato degli antibiotici. Ciò permette di evitare che i batteri siano costantemente confrontati con residui o tracce di antibiotici nel loro ambiente, in modo da riuscire a eliminarli quando vi sono esposti durante i trattamenti. Questa strategia esige diagnosi mediche il più rapide e precise possibile.
I metodi di identificazione tradizionali però richiedono tempo. Consistono nel prelevare i batteri dai pazienti e coltivarli affinché il loro numero diventi sufficiente per procedere ad analisi dettagliate. La fase di crescita dura circa 12 ore per alcune specie, per altre talvolta di più. Le analisi richiedono due ore aggiuntive.
Markus Seeger e il suo team cercano di velocizzare la procedura. «La nostra idea è di riuscire a reperire più rapidamente alcuni batteri, anche in piccole quantità, colorandoli in modo mirato. E cerchiamo di catturarli direttamente nel sangue, per poter aumentare la loro densità e analizzarli più velocemente». Questo approccio non rappresenta una diagnosi esaustiva, ma permette di confermare o meno la presenta di alcuni batteri specifici in modo più rapido rispetto ai metodi tradizionali. Si guadagna così del tempo prezioso, soprattutto in caso di infezioni del sangue, dove non è sempre possibile attendere uno o due giorni in più per ottenere analisi dettagliate.
Il gruppo di ricercatori si è focalizzato sull’identificazione dell’Escherichia coli, un batterio spesso causa di infezioni dell’apparato urinario e, in alcuni casi, anche di infezioni del sangue. Tra il 2004 e il 2024, i tassi di resistenza attestati da questa specie batterica in Svizzera sono aumentati, fino addirittura a quintuplicare per alcune classi di antibiotici. «Sapere se si tratta di Escherichia coli o di qualcos’altro è già un’indicazione molto utile per prendere una prima decisione sul trattamento da somministrare», precisa il biochimico. In questo caso, gli strumenti sviluppati dal team di Seeger permetterebbero di risparmiare circa sei ore rispetto alle dodici richieste dalla diagnostica tradizionale.
Penetrare la «giungla degli zuccheri»
Per andare a pesca dell’Escherichia coli, Markus Seeger e il suo team hanno dovuto risolvere due problemi. Da un lato, bisognava trovare l’esca giusta, vale a dire un elemento specifico e comune a tutti i batteri Escherichia coli. Dall’altro, il ricercatore ammette di aver «sottovalutato la complessità rappresentata dalla giungla di zuccheri che forma una barriera attorno ai batteri». Una giungla molto densa, tanto che solo poche molecole riescono ad attraversarla.
Come amo, i ricercatori hanno deciso di utilizzare anticorpi in miniatura, chiamati nanocorpi (nanobodies). Grazie alle loro dimensioni ridotte, i nanocorpi riescono a passare facilmente tra le ramificazioni degli zuccheri. Inoltre, sono più stabili degli anticorpi tradizionali e a temperatura ambiente conservano più a lungo la loro funzionalità. Si tratta di un fattore chiave per ottenere strumenti di rilevamento che possano essere conservati e trasportati senza la necessità di mantenere la catena del freddo. La squadra di ricercatori ha preso in esame una banca dati internazionale e un altro registro di batteri rilevati negli ospedali svizzeri. Analizzando il genoma dei batteri di tipo Escherichia coli elencati, i ricercatori hanno identificato la proteina OmpA, della quale una forma particolare si trova esclusivamente negli Escherichia coli. In seguito, il gruppo di ricercatori ha sviluppato nanocorpi capaci di riconoscere quella versione di OmpA in modo specifico ed efficace in oltre il 90% dei membri della specie. Quindi, un amo che attira specificamente gli Escherichia coli.
È una soluzione pronta all’uso per colorare i batteri, ma non per pescarli: «Per individuare l’Escherichia coli, il sistema è efficace. Si possono legare delle minuscole molecole di colorante ai nanocorpi, senza che ciò aumenti in modo significativo la loro dimensione», spiega il ricercatore. «Invece, per catturare i batteri utilizziamo delle sfere magnetiche più grandi. Queste però non riuscivano a passare attraverso la giungla di zuccheri che circonda i batteri». I ricercatori hanno quindi sviluppato una vera e propria canna da pesca per il loro kit di rilevamento: un filamento molecolare che collega i nanocorpi – l’amo – alle sfere magnetiche bloccate dagli zuccheri – il manico. «Adesso disponiamo di uno strumento che non solo permette di riconoscere gli Escherichia coli ma anche di catturarli. Spero di riuscire a implementarlo nell’ambito della diagnostica clinica. È una soluzione che stiamo già utilizzando per le analisi ambientali», conclude il biochimico.
Programma nazionale di ricerca «Resistenza antimicrobica» (PNR 72)
Il problema della resistenza agli antibiotici si fa sempre più urgente. Per questo motivo nel 2015 il Fondo nazionale svizzero per la ricerca scientifica (FNS) ha lanciato, su mandato del Consiglio federale, il Programma nazionale di ricerca «Resistenza antimicrobica» (PNR 72), pianificato in collaborazione con la Strategia nazionale contro le resistenze agli antibiotici (StAR).
Nel quadro del Programma, sono stati realizzati 45 progetti: 33 di questi sono stati condotti presso scuole universitarie svizzere, gli altri 12 sono progetti internazionali portati avanti nell’ambito dell’Iniziativa di programmazione congiunta sulla resistenza antimicrobica (Joint Programming Initiative on Antimicrobial Resistance, JPIAMR) avviata su scala europea. Il PNR 72 ha beneficiato di un finanziamento complessivo di 20 milioni di franchi.
Il Programma ha riunito medici, veterinari, biologi ed esperti ambientali che hanno collaborato in modo interdisciplinare. I ricercatori hanno esplorato nuovi approcci per rallentare la diffusione di batteri resistenti agli antibiotici e migliorare i metodi di trattamento.
- I progetti sul portale dati del FNS: 177368 (NRP 72), 187170 (BRIDGE), 170625 (SNSF Professorship)
- Il progetto sul sito del PNR 72 (in inglese)